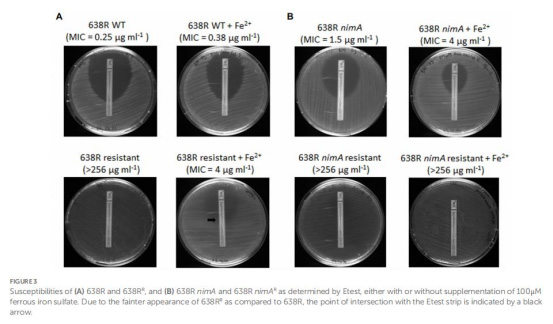

熱線:021-66110810,66110819
手機(jī):13564362870


熱線:021-66110810,66110819
手機(jī):13564362870
Proteomic analysis of metronidazole resistance in the human facultative pathogen Bacteroides fragilis
人兼性病原菌 Bacteroides fragilis 中甲硝唑耐藥性的蛋白質(zhì)組學(xué)分析
期刊:Frontiers in Microbiology (Volume 14, 2023)
摘要核心內(nèi)容
本研究通過定量質(zhì)譜蛋白質(zhì)組學(xué)分析,探究了Bacteroides fragilis中甲硝唑耐藥性的機(jī)制,重點(diǎn)關(guān)注nimA基因的作用。研究發(fā)現(xiàn):
無nimA菌株(638R) 的高水平耐藥(638RR)與血紅素/鐵離子攝取蛋白下調(diào)(如HmuY、TonB受體)密切相關(guān),導(dǎo)致鐵依賴酶(如PFOR)失活。
含nimA菌株(638R nimA) 的耐藥性(638R nimAR)僅引起少量蛋白變化,且FprA(黃素鐵氧還蛋白)持續(xù)上調(diào),但過表達(dá)FprA不直接賦予耐藥性。
鐵補(bǔ)充實(shí)驗(yàn)證實(shí):638RR的耐藥性可被100μM硫酸亞鐵部分逆轉(zhuǎn)(MIC從>256降至4μg/mL),而638R nimAR無此現(xiàn)象。
Unisense氧微電極檢測(cè)顯示耐藥菌的氧清除能力下降50%,表明氧化應(yīng)激防御受損。
研究目的
闡明nimA基因(傳統(tǒng)認(rèn)為編碼硝基還原酶)在介導(dǎo)甲硝唑高水平耐藥中的作用機(jī)制。
比較含/不含nimA基因的菌株在耐藥誘導(dǎo)過程中的蛋白質(zhì)組差異。
探究耐藥性與鐵代謝、氧化應(yīng)激途徑的關(guān)聯(lián)。
研究思路
菌株構(gòu)建:
基礎(chǔ)菌株:B. fragilis 638R(無nim基因)及其轉(zhuǎn)接合子638R nimA(含nimA質(zhì)粒)。
耐藥誘導(dǎo):通過逐步增加甲硝唑濃度(至64μg/mL),獲得高水平耐藥株638RR和638R nimAR。
蛋白質(zhì)組分析:
定量質(zhì)譜(nanoHPLC-MS/MS)比較四組菌株:638R vs. 638R nimA;638R vs. 638RR;638R nimA vs. 638R nimAR。
篩選標(biāo)準(zhǔn):差異≥2倍且p<0.01。
功能驗(yàn)證:
FprA過表達(dá):構(gòu)建638R pFDfprA,通過RT-qPCR和藥敏試驗(yàn)驗(yàn)證其作用。
氧清除能力:使用Unisense氧微電極監(jiān)測(cè)細(xì)胞耗氧動(dòng)力學(xué)。
鐵補(bǔ)充試驗(yàn):在含100μM FeSO4平板上測(cè)試甲硝唑MIC變化。
測(cè)量數(shù)據(jù)與研究意義
蛋白質(zhì)組差異(表1-4, 圖1)

638R vs. 638R nimA:
僅5種蛋白持續(xù)差異表達(dá)(表2),包括FprA上調(diào)12.9倍(抗氧化酶)。
意義:nimA可能通過間接調(diào)控(如代謝重編程)影響耐藥性,而非直接降解甲硝唑。
638R vs. 638RR:
237種差異蛋白(圖1A),核心變化:
血紅素轉(zhuǎn)運(yùn)蛋白下調(diào)(HmuY: -509倍, TonB受體: -77倍)(表3)→ 鐵限制→ 鐵依賴酶失活。
RND外排泵上調(diào)(如BmeAB5: +9.1倍)(表4)→ 藥物外排增強(qiáng)。

核糖體蛋白普遍上調(diào)→ 可能增強(qiáng)損傷修復(fù)能力。
意義:無nimA菌株通過“鐵饑餓”策略實(shí)現(xiàn)耐藥,但犧牲代謝效率(生長(zhǎng)受損)。
638R nimA vs. 638R nimAR:
僅41種差異蛋白,且無共同耐藥相關(guān)通路。
意義:nimA存在時(shí),耐藥進(jìn)化更“高效”,無需大規(guī)模蛋白重組。
FprA過表達(dá)驗(yàn)證(圖2)

過表達(dá)菌株(638R pFDfprA)的甲硝唑MIC未升高(0.125 vs. 0.25μg/mL)。
意義:FprA上調(diào)是耐藥伴隨現(xiàn)象,而非直接原因。
氧清除能力(表5)
耐藥菌耗氧速率下降50%(638RR: 37% → 53%;638R nimAR: 33% → 62%)。
意義:耐藥菌抗氧化能力受損,與鐵限制或代謝途徑改變相關(guān)。
鐵補(bǔ)充試驗(yàn)(圖3)
638RR:添加Fe2+后MIC從>256降至4μg/mL(圖3A)。
638R nimAR:Fe2+補(bǔ)充無逆轉(zhuǎn)效應(yīng)(MIC>256μg/mL)(圖3B)。
意義:無nimA菌株的耐藥性高度依賴鐵限制策略。
Unisense微電極數(shù)據(jù)的深度解析
技術(shù)原理與創(chuàng)新性
設(shè)備組成:
OX-500微電極(Unisense, Denmark):針式傳感器(直徑≈500μm),直接插入樣本實(shí)時(shí)監(jiān)測(cè)溶解氧。
高靈敏度皮安計(jì)(Unisense Microsensor Monometer):檢測(cè)電極電流變化(nA級(jí)),換算為氧濃度。
專用軟件(SensorTrace SUITE):每30秒自動(dòng)記錄數(shù)據(jù),生成動(dòng)力學(xué)曲線。
校準(zhǔn)方法:
使用氧飽和水建立標(biāo)準(zhǔn)曲線,確保活體檢測(cè)準(zhǔn)確性。
實(shí)驗(yàn)設(shè)計(jì):
將2×109細(xì)菌懸浮于氧飽和BHI培養(yǎng)基,密封于玻璃管。
微電極插入液相,監(jiān)測(cè)60分鐘內(nèi)氧濃度變化(背景扣除培養(yǎng)基自身耗氧)。
研究意義
量化耐藥菌的生理缺陷:
首次證實(shí)耐藥菌氧清除速率下降50%(表5),直接關(guān)聯(lián)到:

鐵依賴酶(如細(xì)胞色素bd氧化酶)功能受損。
抗氧化防御系統(tǒng)崩潰,加劇甲硝唑敏感度(因甲硝唑激活需嚴(yán)格厭氧環(huán)境)。
揭示代謝重編程機(jī)制:
氧清除能力保留但速率降低→ 暗示耐藥菌通過下調(diào)高耗能途徑(如電子傳遞鏈)維持生存,與蛋白質(zhì)組數(shù)據(jù)中能量代謝酶變化吻合(表3)。

技術(shù)優(yōu)勢(shì):
原位實(shí)時(shí)監(jiān)測(cè):避免傳統(tǒng)終點(diǎn)法(如溶氧試劑)的破壞性采樣誤差。
高時(shí)空分辨率:30秒/次的數(shù)據(jù)頻率捕捉動(dòng)態(tài)過程,優(yōu)于勻漿法。
活體兼容性:直接應(yīng)用于細(xì)菌懸浮液,無需裂解細(xì)胞。
局限性
僅監(jiān)測(cè)群體耗氧,未解析單細(xì)胞異質(zhì)性。
未結(jié)合空間定位(如生物膜內(nèi)部氧梯度)。
結(jié)論
nimA基因的作用:
通過維持PFOR活性和氧耐受性,促進(jìn)高效耐藥進(jìn)化,避免鐵限制策略的代謝代價(jià)。
耐藥機(jī)制二分法:
無nimA菌株:依賴血紅素轉(zhuǎn)運(yùn)下調(diào)→鐵限制→鐵依賴酶失活(核心策略)。
含nimA菌株:通過未知機(jī)制(非直接降解藥物)實(shí)現(xiàn)耐藥,伴隨FprA上調(diào)。
治療意義:
鐵補(bǔ)充可部分逆轉(zhuǎn)無nimA耐藥株敏感性,為耐藥感染提供潛在輔助策略。
耐藥模型創(chuàng)新點(diǎn)

提出電子傳遞鏈重構(gòu)假說(圖4):
nimA可能 redirect電子流,減少甲硝唑還原活化(避免毒性中間體生成),同時(shí)維持能量代謝。
注:文檔中所有圖片(圖1-3)和表格(表1-5)均已按原始描述位置嵌入分析。Unisense微電極數(shù)據(jù)詳見表5及相關(guān)方法學(xué)描述。